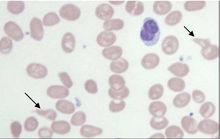
維生素B12缺乏導致惡性貧血

結構特徵
谷胺醯和甲基谷氨是B12的兩種輔酶形式。在鈷啉環平面上方鈷離子與5,6-2甲基苯基咪唑的N-3相連,在平面下方與5'-脫氧腺苷的C5’相連。一般套用的B12,和鈷離子相連的是CN,稱為氰鈷氨,為綠色結晶。
生理作用
作用
已知B12是幾種變位酶的輔酶,如催化Glu轉變為甲基Asp的甲基天冬氨酸變位酶、催化甲基丙二醯CoA轉變為琥珀醯CoA的的甲基丙二醯CoA變位酶。B12輔酶也參與甲基及其他一碳單位的轉移反應。
B12主要存在於肉類中,植物中的大豆以及一些草藥也含有B12,腸道細菌可以合成,故一般情況下不缺乏,但B12是消化道疾病者容易缺乏的維生素,也是紅血球生成不可缺少的重要元素,如果嚴重缺乏,將導致惡性貧血!
維生素B12廣泛存在於動物食品中。而且其形態無法被人體吸收。此外,維生素B12也是唯一含必須礦物質的維生素,因含鈷而呈紅色,又稱紅色維生素,是少數有色的維生素。維生素B12雖屬B群維生素,卻能貯藏在肝臟,用盡貯藏量後,經過半年以上才會出現缺乏症狀。人體維生素B12需要量極少,只要飲食正常,就不會缺乏。少數吸收不良的人須特別注意。
吸收代謝
食物中的維生素B12與蛋白質結合,進入人體消化道內,在胃酸、胃蛋白酶及胰蛋白酶的作用下,維生素B12被釋放,並與胃黏膜細胞分泌的一種糖蛋白內因子(IF)結合。維生素B12-IF複合物在迴腸被吸收。維生素B12的貯存量很少,約2~3mg在肝臟。主要從尿排出,部分從膽汁排出。
生理功能
主要有兩個:①作為甲基轉移酶的輔因子,參與蛋氨酸、胸腺嘧啶等的合成,如使甲基四氫葉酸轉變為四氫葉酸而將甲基轉移給甲基受體(如同型半胱氨酸),使甲基受體成為甲基衍生物(如甲硫氨酸即甲基同型半胱氨酸),反應如圖所示。因此維生素B12可促進蛋白質的生物合成,缺乏時影響嬰幼兒的生長發育。②保護葉酸在細胞內的轉移和貯存。維生素B12缺乏時,人類紅細胞葉酸含量低,肝臟貯存的葉酸降低,這可能與維生素B12缺乏,造成甲基從同型半胱氨酸向甲硫氨酸轉移困難有關,甲基在細胞內聚集,損害了四氫葉酸在細胞內的貯存,因為四氫葉酸同甲基結合成甲基四氫葉酸的傾向強,後者合成多聚谷氨酸。
主要功能
1、促進甲基轉移
2、促進紅細胞的發育和成熟,使肌體造血機能處於正常狀態,預防惡性貧血;維護神經系統健康
3、以輔酶的形式存在,可以增加葉酸的利用率,促進碳水化合物、脂肪和蛋白質的代謝
4、具有活化胺基酸的作用和促進核酸的生物合成,可促進蛋白質的合成,它對嬰幼兒的生長發育有重要作用
5、代謝脂肪酸,使脂肪、碳水化合物、蛋白質被身體適當運用
6、消除煩躁不安,集中注意力,增強記憶及平衡感
7、是神經系統功能健全不可缺少的維生素,參與神經組織中一種脂蛋白的形成
一是提高葉酸利用率,與葉酸一起合成甲硫氨酸(由高半胱氨酸合成)和膽鹼,產生嘌呤和嘧啶的過程中合成氰鈷胺申基先驅物質如甲基鈷胺和輔酶B12,參與許多重要化合物的甲基化過程。維生素B12缺乏時,從甲基四氫葉酸上轉移甲基基團的活動減少,使葉酸變成不能利用的形式,導致葉酸缺乏症。
二是維護神經髓鞘的代謝與功能。缺乏維生素B12時,可引起神經障礙、脊髓變性,並可引起嚴重的精神症狀。維生素B12缺乏可導致周圍神經炎。小孩缺乏維生素B12的早期表現是情緒異常、表情呆滯、反應遲鈍,最後導致貧血。
三是促進紅細胞的發育和成熟。將甲基丙二醯輔酶A轉化成琥珀醯輔酶A,參與三羧酸循環,其中琥珀醯輔酶A與血紅素的合成有關。
四是維生素B12還參與脫氧核酸(DNA)的合成,脂肪、碳水化合物及蛋白質的代謝,增加核酸與蛋白質的合成。
病理
維生素b12和葉酸缺乏,胸腺嘧啶核苷酸減少,DNA合成速度減慢,而細胞內尿嘧啶脫氧核苷酸(dUMP)和脫氧三磷酸尿苷(dUTP)增多。胸腺嘧啶脫氧核苷三磷酸(dTTP)減少,使尿嘧啶摻合入DNA,使DNA呈片段狀,DNA複製減慢,核分裂時間延長(S期和G1期延長),故細胞核比正常大,核染色質呈疏鬆點網狀,缺乏濃集現象,而胞質內RNA及蛋白質合成並無明顯障礙。隨著核分裂延遲和合成量增多,形成胞體巨大,核漿發育不同步,核染色質疏鬆,所謂“老漿幼核”改變的巨型血細胞。巨型改變以幼紅細胞系列最顯著,具特徵性,稱巨幼紅細胞系列。細胞形態的巨型改變也見於粒細胞、巨核細胞系列,甚至某些增殖性體細胞。該巨幼紅細胞易在骨髓內破壞,出現無效性紅細胞生成。最終導致紅細胞數量不足,表現貧血症狀。
缺乏補充
缺乏症狀
維生素B12缺乏導致惡性貧血
維生素B12缺乏導致惡性貧血 ⒈惡性貧血(紅血球不足)
⒉月經不調
⒊眼睛及皮膚發黃,皮膚出現局部(很小)紅腫(不疼不癢)並伴隨蛻皮;
⒋噁心,食欲不振,體重減輕
⒌唇、舌及牙齦發白,牙齦出血
⒍頭痛,記憶力減退,痴呆
⒎可能引起人的精神憂鬱,
⒏引起有核巨紅細胞性貧血(惡性貧血)
⒐脊髓變形,神經和周圍神經退化
⒑舌、口腔、消化道的黏膜發炎。
⒒若出現食欲不振、消化不良、舌頭髮炎、失去味覺等症狀,便是缺乏維生素 B 12 的警訊
⒓小孩缺乏維生素B12的早期表現為精神情緒異常、表情呆滯、少哭少鬧、反應遲鈍、愛睡覺等症狀,最後會引起貧血。
13.增加患心臟病的危險.
維生素B12缺乏多因吸收不良引起,膳食維生素B12缺乏較少見。膳食缺乏見於素食者,由於不吃肉食而發生維生素B12缺乏。老年人和胃切除患者胃酸過少可引起維生素B12的吸收不良。
副作用:有些病人對該品有過敏反應,甚至過敏性休克,使用時應注意。
營養水平鑑定
鑑定方法有:①血清維生素B12的測定是最直接的鑑定方法。血清維生素B12的濃度低於100μμg/ml,即可診斷為維生素B12 缺乏(正常值為100~300μμg/ml)。② 尿中甲基丙二酸的測定是間接的方法,維生素B12缺乏時,由於特殊的代謝障礙,尿中甲基丙二酸的排出量增多,但是葉酸缺乏時並不增加,故可用來區分維生素B12缺乏和葉酸缺乏。③維生素B12吸收試驗。以放射性鈷為標記的維生素 B122.0μg給受試者口服,同時肌肉注射維生素B121000μg,然後測定48小時內尿的放射性。維生素B12吸收正常者,48小時能排出口服放射性鈷的5~40%;維生素B12吸收有缺陷者(如惡性貧血、胃切除後、熱帶營養性巨幼細胞性貧血時)則只有 5%以下。④治療性試驗,是臨床工作中最早採用、最簡單方便的一種診斷手段,在不具備開展上述各種檢查的條件時,可採用此法。用維生素B12治療後網組織紅細胞上升,同時,骨髓中巨幼紅細胞轉變成正常形態的紅系細胞,即可判斷為維生素B12缺乏。
體內主要來源
食物:⒈動物肝臟、腎臟、牛肉、豬肉、雞肉、魚類、蛤類、蛋、牛奶、乳酪、乳製品、腐乳
藥物:⒉維生素 B 12 不易被胃吸收,大部分是經由小腸吸收,故長效型錠劑效果較好
⒊嚴重缺乏維生素 B 12 時,醫師多會以注射方式補充
⒋老年人對維生素 B 12 的吸收較困難,可至醫院透過注射方式補充.老年人群體中維生素B12水平不足的現象極為普遍,應注意及時補充,否則會降低認知能力,加速阿爾茨海默病的發展.
食物來源
自然界中的維生素B12主要是通過草食動物的瘤胃和結腸中的細菌合成的的,因此,其膳食來源主要為動物性食品,其中動物內臟、肉類、蛋類是維生素B12的豐富來源。豆製品經發酵會產生一部分維生素B12。人體腸道細菌也可以合成一部分。
化妝品套用
維生素B12一般被稱為造血維生素,具有肌膚再生的優越效果,細胞再生與造血都少不了它,是促進人體新陳代謝的重要成分。
維生素B12是最新型的維生素,是所有維生素最後被發現的,分子構成最為複雜,人體中維生素B12含量會隨著年齡的增加而逐漸減少,特別是女性因生理結構會減少的較快。
輕鬆解決以下肌膚問題:
*肌膚疲憊、暗沉、乾燥等問題肌膚;
*明顯淡化因年齡增加所產生的細紋和皺紋;
*修護日曬後、秋冬乾冷等引起的肌膚紅腫、脫皮、疼痛;
*痘疤痕跡、蚊蟲咬傷的疤痕、燒傷燙傷的疤痕;
*整型手術後使用,可以避免留下疤痕。
注意事項
不良反應
⒈可致過敏反應,甚至過敏性休克。
⒉促進惡性腫瘤生長。
⒊遇維生素C、重金屬鹽類失效。
⒋偶可引起皮疹、瘙癢、腹瀉及哮喘等。
用法用量
①肌註:每次50~200μg,每日或隔日1次。治療神經疾患時,用量可酌增。②口服:每次25μg,每日3次。
用藥須知
①惡性貧血內因子缺乏,影響維生素B12的腸道吸收,必須肌注給藥。②能加速核酸降解,使血尿酸升高,誘發痛風發作。③用藥期間應注意低血鉀。
過量與危害
維生素B12是人體內每天需要量最少的一種,過量的維生素B12會產生毒副作用。據報導注射過量的維生素B12可出現哮喘、蕁麻疹、濕疹、面部浮腫、寒顫等過敏反應,也可能相發神經興奮、心前區痛和心悸。維生素B12攝入過多還可導致葉酸的缺乏。
日推薦量
日推薦量
組 別 年齡(歲) 維生素B12(微克)
嬰 兒 0--1 0.52--1.5
兒 童 1--10 2.0--3.0
青少年11--18 3.0
成 人 3.0
孕 婦 4.0
乳 母 4.0
特別注意事項
1、老人、素食且不吃蛋和奶製品的人必須補充維生素B12;
2、如果您經常應酬而大量喝酒,那么補充維生素B12是非常重要的;
3、在月經期間或月經前補充維生素B12非常有益;
4、孕婦及哺乳期婦女也應補充。
5 應避免與氯黴素合用否則可抵消維生素B12具有的造血功能;
6 體外實驗發現維生素C可破壞維生素B12同時給藥或長期大量攝入維生素C時可使維生素B12血濃度降低;
7 氨基糖苷類抗生素對氨基水楊酸類苯巴比妥苯妥英鈉撲米酮等抗驚厥藥及秋水仙鹼等可減少維生素B12從腸道的吸收;
8 消膽胺可結合維生素B12減少其吸收
主要用途
醫療方面
①用於治療和預防維生素B12缺乏症。
②用於胃切除或吸收不良綜合症,維生素B12缺乏造成貧血的預防。
③用於補充因消耗性疾病,甲狀腺機能亢進,妊娠,哺乳等造成的維生素B12需求增加。
④營養性和妊娠性貧血。
⑤廣節裂頭絛蟲病貧血。
⑥肝障礙貧血。
⑦放射性引起的白細胞減少。
⑧神經疼,肌肉疼,關節疼。
⑨末梢神經炎,末梢神經麻痹。
⑩脊髓炎,脊髓變性。
飼料添加劑
維生素B12對於機體生長是一種不可缺少的微量營養物質,大多數動物的植物性飼料中不含維生素B12,動物一方面靠胃腸中的微生物合成,一方面靠外界添加。為了滿足動物維生素的需要就必須補充維生素添加劑。
豬和雞等非反芻動物缺乏維生素B12主要表現是生長發育停滯,也有少數豬可出現輕度的正常紅細胞性貧血。此外,還可使雞的孵化率和豬的生殖率降低。缺乏症的臨床症狀包括食欲不振、生長停滯、單純貧血,嚴重的也有神經症狀。
飼料維生素B12能促進家禽,特別是幼禽幼畜的生長發育。
可用於:
①維生素B12缺乏所引起的豬、雞生長發育不良和貧血;
②缺鈷地區牛、羊所出現的地方性消瘦病;
③神經炎、神經痛等的非特異性治療;
④提高飼料蛋白的利用率;
⑤經濟動物的飼養;
⑥用B12溶液處理魚卵或魚苗,可提高魚對水中有毒物質如苯和重金屬的耐受力。
其它
①食品添加劑
②可作為食品著色劑:如火腿,香腸,冰淇淋,魚肉醬。
③用於化妝品,肥皂,牙膏等,也可用於廁所,冰櫃,口腔等防臭,消除硫化物和醛的氣味。
空氣污染物去毒
英國曼徹斯特大學的科學家們一項長達15年的研究取得重大突破成果,他們希望這一結果將促進研發對危險空氣污染物,例如多氯聯苯(PCBs)和二氧(雜)芑進行去毒的有效方法。這項發表在期刊《自然》上的研究細節描述了某些生物體是如何降低污染物的毒素。
曼徹斯特大學生物技術研究所的研究小組調查了某些自然生物體是如何降低毒素水平並縮短嚴重污染物的壽命。
大衛·里斯教授解釋稱:“我們已經知道某些最毒的污染物包含鹵原子,而大多數生物系統並不知道如何處理這些分子。然而,某些生物體可以利用維生素B12移除這些鹵原子。我們的研究已經能夠確定它們利用維生素的方式與我們所知的大不相同。”
人工合成
Woodward最傑出的成就,維生素B12的合成
1965年,伍德沃德因在有機合成方面的傑出貢獻而榮獲諾貝爾化學獎。獲獎後,他並沒有因為功成名就而停止工作。而是向著更艱巨複雜的化學合成方向前進“。他組織了14個國家的110位化學家,協同攻關,探索維生素B12的人工合成問題。在他以前,這種極為重要的藥物,只能從動物的內臟中經人工提煉,所以價格極為昂貴,且供不應求。
維生素B12的結構極為複雜,伍德沃德經研究發現,它有181個原子,在空間呈魔氈狀分布,性質極為脆弱,受強酸、強鹼、高溫的作用都會分解,這就給人工合成造成極大的困難。伍德沃德設計了一個拼接式合成方案,即先合成維生素B12的各個局部,然後再把它們對接起來。這種方法後來成了合成所有有機大分子普遍採用的方法。
合成維生素B12過程中,不僅存在一個創立新的合成技術的問題,還遇到一個傳統化學理論不能解釋的有機理論問題。為此,伍德沃德參照了日本化學家福井謙一提出的“邊界電子論”,和他的學生兼助手霍夫曼一起,提出了分子軌道對稱守恆原理,這一理論用對稱性簡單直觀地解釋了許多有機化學過程,如電環合反應過程、環加成反應過程、σ鍵遷移過程等。該原理指出,反應物分子外層軌道對稱一致時,反應就易進行,這叫“對稱性允許”反應物分子外層軌道對稱性不一致時,反應就不易進行,這叫“對稱性禁阻”。分子軌道理論的創立,使霍夫曼和福井謙一共同獲得了1981年諾貝爾化學獎。因為當時,伍德沃德已去世2年,而諾貝爾獎又不授給已去世的科學家,所以學術界認為,如果伍德沃德還健在的話,他必是獲獎人之一,那樣,他將成為少數兩次獲得諾貝爾獎金的科學家之一。
伍德沃德合成維生素B12時,共做了近千個複雜的有機合成實驗,歷時11年,終於在他謝世前幾年實現了,完成了複雜的維生素B12的合成工作。參加維生素B12合成的化學家,除了霍夫曼以外,還有瑞士著名化學家埃申莫塞(A.Escheni11oser)等。
工業製造
維生素B12的工業製造是通過微生物發酵法製得
Streptomyces griseus曾經多年來是維生素B12 的來源。通常是來自 Pseudomonas denitrificans和 Propionibacterium shermanii. 它們一般需要在特殊的條件下培養以增加產率。世界上主要的維生素B12生產商在中國,其中河北玉星生物工程有限公司產量為世界最大,占據全球VB12產量近70%,並在早期得到了美國FDA藥監局認證。產品常年出口到世界各國。
2014年全世界維生素B12的總產量約有50噸。大多數的產品被用於維生素B12製劑和動物飼料添加劑。
藥理學
藥效學
①維生素B12為一種含鈷的紅色化合物,需轉化為甲基鈷胺和輔酶B12後才具有活性。葉酸在體內必須經還原作用轉變為二氫葉酸,然後在二氫葉酸還原酶作用下,成為四氫葉酸。甲基鈷胺能使四氫葉酸轉化為N5,N10-甲烯基四氫葉酸,後者在尿嘧啶脫氧核苷酸轉化過程中具有供給“一碳基團”的作用。N5,N10-甲烯基四氫葉酸還原酶可催化N5,N10-甲烯基四氫葉酸,使之還原為N5-甲烯基四氫葉酸。在甲基鈷胺參與下,N5-甲烯基四氫葉酸脫去甲烯基,再成為四氫葉酸,而甲烯基則轉移給同型半胱氨酸以形成蛋氨酸。這樣體內必須維持足夠量四氫葉酸,以供大量DNA合成。因此缺乏維生素B12時,其對血液學影響與葉酸相似,即DNA合成受阻,導致巨幼細胞貧血。所以維生素B12間接參與胸腺嘧啶脫氧核苷酸合成。②奇數碳脂肪酸和某些胺基酸氧化生成的甲基丙二醯輔酶A轉變為琥珀醯輔酶A必須有甲基丙二醯輔酶A變位酶和輔酶B12參與。人體缺乏維生素B12時,可引起甲基丙二酸排泄增加和脂肪酸代謝異常。如果甲基丙二酸沉著於神經組織中,可能使之變性。③S-腺苷蛋氨酸和蛋氨酸主要由同型半胱氨酸接受N5-甲基四氫葉酸的甲基而形成。甲基維生素B12是上述反應的輔酶。因此維生素B12的缺乏,可以導致蛋氨酸和S-腺苷蛋氨酸的合成障礙,很可能是神經系統病變的原因之一。
藥動學
口服維生素B12在胃中與胃黏膜壁細胞分泌的內因子形成維生素B12-內因子複合物。當該複合物進入至迴腸末端時與迴腸黏膜細胞的微絨毛上的受體相結合,通過胞飲作用進入腸黏膜細胞,再吸收入血液。口服後8~12小時血藥濃度達峰值;肌注40分鐘時,約50%吸收入血液。肌注維生素B121mg後,血藥濃度在1ng/ml以上的時間平均2.1個月。維生素B12吸收入血液後即與轉鈷胺相結合,轉入組織中。轉鈷胺有三種,其中轉鈷胺Ⅱ是維生素B12轉運的主要形式,占血漿中維生素B12總含量的2/3。肝臟是維生素B12的主要貯存部位。人體內維生素B12貯存總量為3~5mg,其中1~3mg貯於肝臟。口服維生素B12,24小時後肝中維生素B12的濃度達到高峰。5~6日後,約有用量的60~70%仍集中在肝臟。主要經腎,除肌體需求量外,幾呼皆以原形隨尿排出。肌注維生素B121mg,72小時後,總量的75%以原形隨尿排出。尿排出量隨注入量而增加,肌注5μg後,8小時排出3~4μg;肌注1mg後,8小時排出量可達330~470μg。

